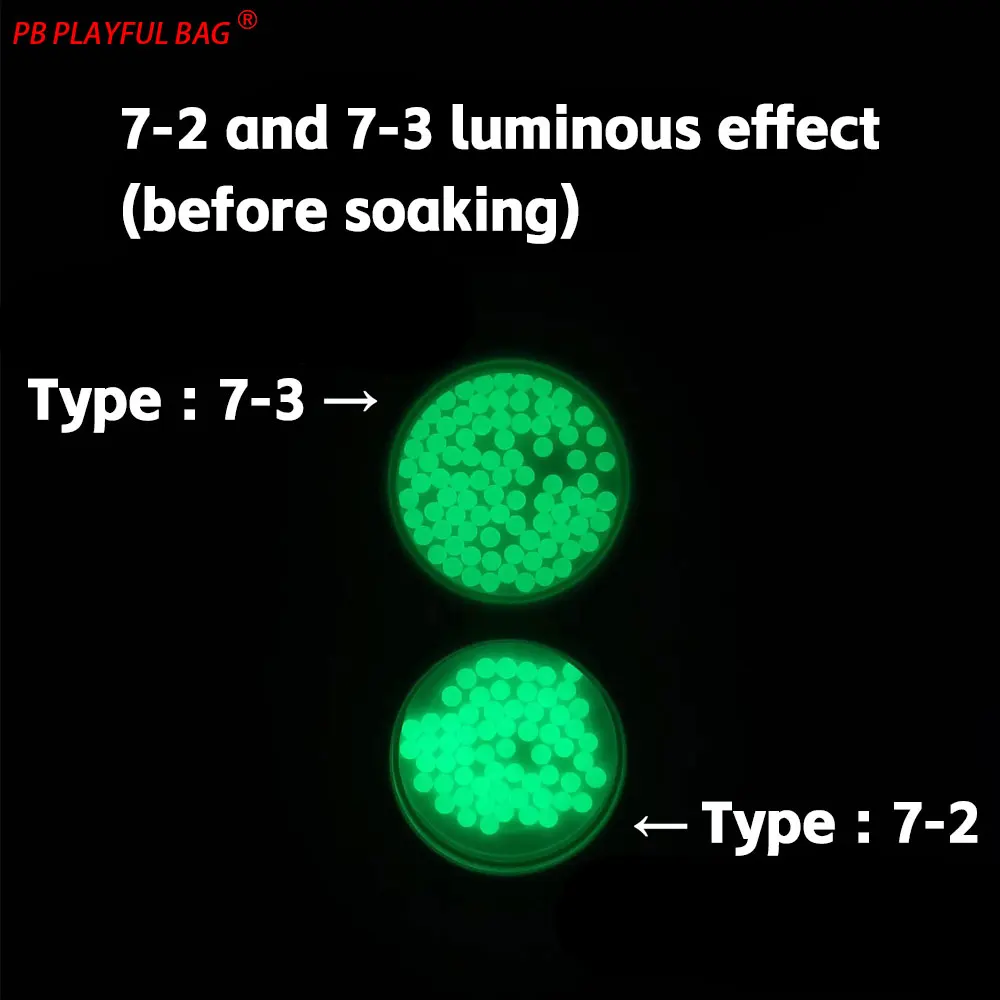

1KG 7-8MM 빛나는 젤 볼 글로우 인 다크 장난감 총 탄약 물 흡수 비즈 도매 QJ99
₩ 88,845.46
₩ 104,527.60
Save ₩ 15,682.14
-15%
IN STOCK
저렴하고 할인된 1KG 7-8MM 빛나는 젤 볼 글로우 인 다크 장난감 총 탄약 물 흡수 비즈 도매 QJ99 도매. Playful World Store에서 직접 구매하세요.
다음 혜택을 누리십시오.
🤑 ₩ 15,682.14 저장
📦 전 세계 무료 배송
❤️ 고품질
🏠 간편한 반품
💰 환불 보장
명세서
SKU:
ATS1005008936386728
가게:
Playful World Store
범주:
완구 및 취미
하위 카테고리:
야외 오락 및 스포츠
할인:
-15%
절약:
₩ 15,682.14
배송비:
무료